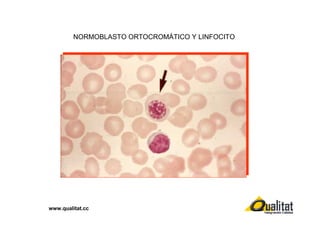
NORMOBLASTO ORTOCROMÁTICO Y LINFOCITO

www.qualitat.cc
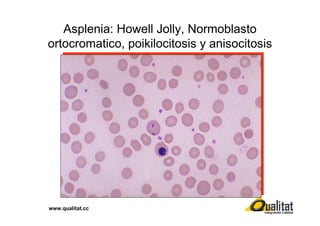
Asplenia: Howell Jolly, Normoblasto
ortocromatico, poikilocitosis y anisocitosis

www.qualitat.cc
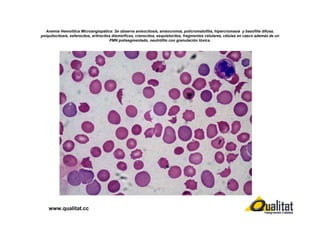
Anemia Hemolítica Microangiopática: Se observa anisocitosis, anisocromia, policromatofilia, hipercromasia y basofilia difusa,
poiquilocitosis, esferocitos, eritrocitos dismórficos, crenocitos, esquistocitos, fragmentos celulares, células en casco además de un
PMN polisegmentado, neutrófilo con granulación tóxica.

www.qualitat.cc
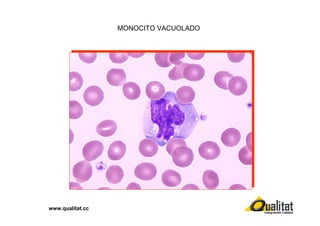
MONOCITO VACUOLADO

www.qualitat.cc

Este documento presenta varias imágenes de hematología a través de laminillas de sangre periférica y médula ósea. Incluye fotos de eritrocitos, linfocitos, plaquetas, normoblastos, eritroblastos y otras células sanguíneas, así como resúmenes breves de varias enfermedades hematológicas como anemia, leucemia y otras.